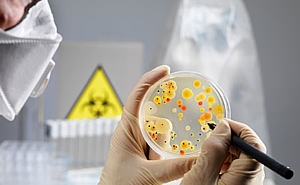

За распространение холеры в Мариуполе возбуждено уголовное дело
Мариупольская милиция предварительно установила, что в городе были нарушены санитарные правила по предупреждению эпидемических заболеваний.
Мариупольская милиция предварительно установила, что в городе были нарушены санитарные правила по предупреждению эпидемических заболеваний.
В Мариуполе возбуждено уголовное дело по факту распространения холеры среди местного населения.
По данным Мариупольского городского управления милиции, дело возбуждено по статье 325 Уголовного кодекса ("нарушение правил борьбы с эпидемиями").
Правоохранители отметили, что в конце мая из городской санитарно-эпидемиологической службы в милицию поступили сообщения о заболевании холерой нескольких жителей города.
По данным фактам была осуществлена проверка, и предварительно было установлено, что на территории Мариуполя лицами, в обязанности которых входит выполнение правил и норм по предупреждению эпидемических и других инфекционных заболеваний, были нарушены эти санитарные правила.
В результате в городе были зарегистрированы случаи заболевания холерой, которая относится к группе острых кишечных инфекций.
Как известно, общее число заболевших холерой - 16, из которых 15 - в Мариуполе. Согласно выводам санэпидемстанции, источником вспышки холеры в Донецкой области стали канализационные стоки.
Врачи не исключают массового распространения холеры в других регионах. Холероподобные вибрионы нашли в Днепре, а также в водоемах Мелитополя и Бердянска.
TCH.ua
Хочете отримувати головне в месенджер? Підписуйтеся на наш
Telegram.
Теги: холера, инфекция, уголовное дело









